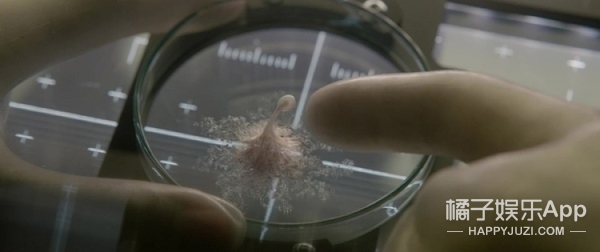

看完这8部密室电影,我的幽闭恐惧症都要犯了
2017年06月13日 21:59:16
来源:橘子娱乐
原标题:看完这8部风格迥异的的密室电影,我的幽闭恐惧症都要犯了! 密室类电影是一个经久不衰的题材。 这类电影情节紧张,把一群人关在一个封闭的空间里,因为矛盾的激化,让大家互相厮打。 今天橘子君给
原标题:看完这8部风格迥异的的密室电影,我的幽闭恐惧症都要犯了!
密室类电影是一个经久不衰的题材。
这类电影情节紧张,把一群人关在一个封闭的空间里,因为矛盾的激化,让大家互相厮打。
今天橘子君给大家推荐8部密室电影,看完后简直幽闭恐惧症都犯了!
1,不要随便得罪同事《贝尔科实验室》

电影在一个无比正常的工作日里,大家突然发现被锁在了公司。
广播里播放了一则通知,每个人都被指派了杀人的任务。
好可怕!本来相亲相爱的同事突然被关在一起自相残杀。

大家先没当回事,然后慌乱,最后为了活命每个人都拿起了武器。

在这场密室猎杀的游戏里,还有人通过摄像头监视着他们的一举一动,幕后主使似乎就是公司的高层?

2,不要随便去奇怪的地方面试《终极面试》

某背景神秘的大集团进行了一场面试,有8名精英入围。

奇怪的是这场面试并没有考官,只有三条规则:1不能与警卫交谈,2不能离开房间,3不能污损考卷。这8名精英就被关在房间里开始猜测公司的意图。

这8个人身份,性格,种族都各有不同,最后面试竟然发生到了见血的地步,与其说这是一场面试不如说这是一场人性的考验。

3,坐电梯也这么可怕的《电梯里的恶魔》

被困在电梯是很恐怖,但更恐怖的是和不认识的人被困在电梯里。
《电梯里的恶魔》讲述三男两女被困在电梯里。

维修人员一时无法解决故障,在封闭的电梯里,5个人开始焦躁起来,这时电梯突然停电了十几秒,再次亮灯的时候,其中一个人被捅伤了,没有人知道是谁干的。

第二次电梯的灯熄灭又亮起后,又一个人直接被捅死了!凶手就在剩下的四个人之间,他们能在被救出前抓到凶手吗?

4上太空睡觉也这么可怕的《太空旅客》

男主本来打算在飞船的休眠舱睡个120年,醒来后正好到达另一个星球。因为一次意外,他被迫从休眠舱醒来,为了不孤独地度过剩下的89年,她唤醒了另一位女乘客,两人产生了爱情。
关注橘子娱乐 微 信 公 众 号 :(juziyule),发送“电影资源”,获取橘子君推荐电影资源,坐在家里看经典大片!

就在他们培养感情的时候,飞船的操作系统发生了瘫痪,这次的问题就不仅仅是他们两人了,而关系到整个飞船和航行。

谁能想到呢?女主本来打算上太空睡一觉,都会遇到这么多事,太空旅行真是太危险了。
5.不要把外星生物当宠物养的《异星觉醒》

前段时间上映的《异星觉醒》跟《异形》挺像的,都是一只从细胞慢慢长大的怪物在飞船里凶残作恶的故事。
不同的是,《异形》一开始所以人就感受到了威胁,而《异星觉醒》里宇航员一开始竟然把外星生物当宠物一样养着!还给它取了个名字?!
上太空的人心真大啊!
最后这个生物就越长越大,越长越大,在封闭的飞船里把宇航员们给团灭了.....


6一个人一口棺材也可以很好看的《活埋》

电影讲述一位美国人在伊拉克被绑架后不省人事,醒来后发现自己在一口棺材中,陪伴他的只有手机,打火机,电筒,小洞和笔,他能不能用这些东西逃生呢?

《活埋》将密室电影做到了极致,不仅全程只有男主一个人,连空间都十分狭小,不会有太多的景别,可以说是男主的独角戏!

7.人性+血腥+惊悚的《心慌方》

又是一个一觉醒来就发现被关在密室的电影!这种正正方方的密室让人觉得十分压抑。

被关的人有警官,医生,还有数学系大学生和监狱传感器专家,这几个人将用自己的知识合力解开一个个方块密室里的机关和谜题。

每一个密室都有不同的机关,他们能活着出来吗?
8.美国80年代中学生酸甜苦辣的《早餐俱乐部》
说了这么多惊悚题材,橘子君来推荐一部喜剧《早餐俱乐部》。

电影的主角是一群中学生,因为在学校里调皮捣蛋在假期被罚留校,这5个学生家庭背景和性格各异,但通过争吵变成了心意互通的好朋友。

80年代的美国中学生穿得好潮↑
《早餐俱乐部》是一部青春喜剧电影,但却准确挖掘出了中学生的心态,属于那种刚开始觉得很吵但越看越有味道的电影,还伴随着大量的80年代摇滚乐做配乐,很好听。

最后一句

凤凰资讯官方微信
视频
-
李咏珍贵私人照曝光:24岁结婚照甜蜜青涩
播放数:145391
-
金庸去世享年94岁,三版“小龙女”李若彤刘亦菲陈妍希悼念
播放数:3277
-
章泽天棒球写真旧照曝光 穿清华校服肤白貌美嫩出水
播放数:143449
-
老年痴呆男子走失10天 在离家1公里工地与工人同住
播放数:165128



